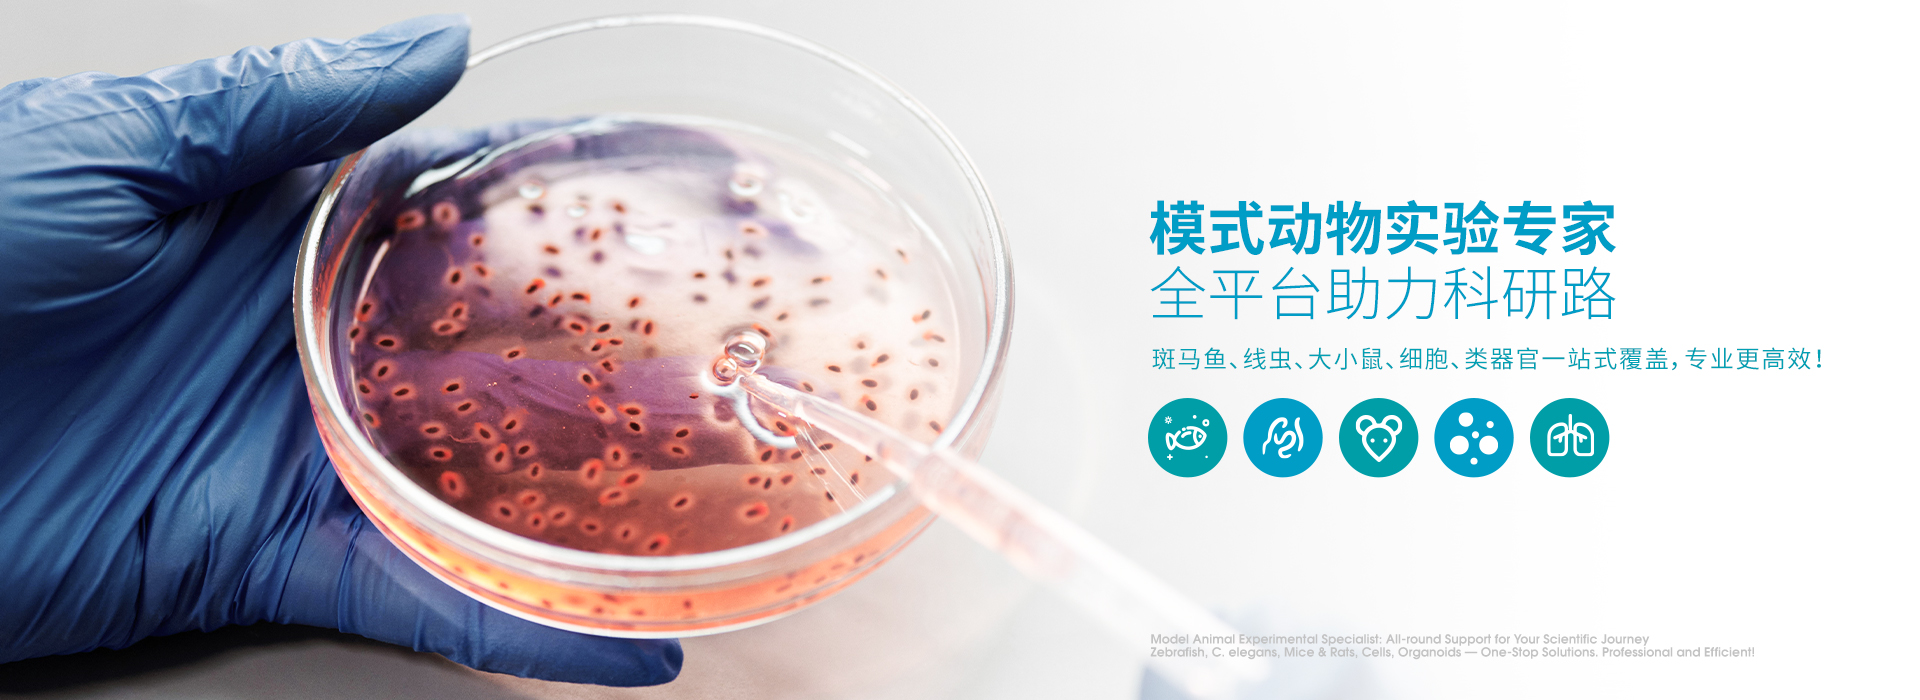

业务咨询
产品&服务
Products & Services
走进百环
Company Profile
百环生物立足打造“科学循证测评+食品功能评价+药理药效研究+精选原料”全生命周期服务科技平台,公司协同AI分子本草、线虫、无菌动物(蜜蜂+小鼠)、斑马鱼、哺乳动物、人体试食的“多位一体”的综合性技术服务平台,提供AI智能配方开发、功效研究、机制研究、科学循证、注册申报、科技营销、安全评价等全方位技术服务。
新闻资讯
News Information